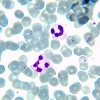
Микроскоп биологический MAGUS Bio 230BL

Микроскоп MAGUS Bio 230BL отлично подходит для исследования биологических образцов в рамках рутинной лабораторной или научно-исследовательской работы. С ним можно изучать полупрозрачные и прозрачные образцы в проходящем светодиодном свете. Микроскоп имеет ахроматическую оптику и продуманную конструкцию для настройки под разные условия наблюдений и под разных пользователей. Для микроскопа разработана линейка аксессуаров, которые позволяют увеличить диапазон кратности, получить больше увеличений внутри диапазона, использовать для наблюдений методы темного поля, поляризованного света и фазового контраста.
Оптическая схема
Оптика построена на базе объективов-ахроматов с корректировкой на бесконечность. В комплектацию включены 4 объектива, всего в револьверное устройство можно установить 5 объективов одновременно. Револьвер находится в положении «от наблюдателя», поэтому пространство над столиком свободно, а пользователю хорошо виден объектив, выбранный для работы.
Микроскоп оснащен бинокулярной визуальной насадкой. Диоптрийная коррекция выполняется на левом окулярном тубусе, в него же можно установить цифровую камеру (приобретается отдельно). Окулярные тубусы вращаются на 360° для подстройки высоты выходного зрачка под рост наблюдателя.
Оптика микроскопа рассчитана на бесконечность, в базовой комплектации наблюдения ведутся на увеличении от 40 до 1000 крат. С опциональными окулярами верхний предел кратности повышается до 1500х, 1600х или 2000х.
Система освещения
Для освещения рабочей области используется светодиод мощностью 3 Вт с долгим сроком работы – около 50 000 часов. Изменение яркости освещения не изменяет его цветовую температуру. Благодаря наличию полевой диафрагмы можно использовать метод Кёлера при настройке освещения. А в специальный слот конденсора можно устанавливать слайдеры: темного поля или фазового контраста. Использование слайдеров ускоряет переключение между разными методами исследования и делает работу с микроскопом более удобной.
Механика
У предметного столика нет выдвижной рейки, а препаратоводитель можно снять при ручном сканировании. Перемещение образца по столику осуществляется плавно. В нижней части корпуса находятся коаксиальные рукоятки грубой и тонкой фокусировки. Для грубой фокусировки предусмотрены регулировка жесткости хода и блокировка. Фокусировочный механизм отзывчивый, при настройке не требуются лишние усилия.
Аксессуары
В линейку аксессуаров, совместимых с микроскопом MAGUS Bio 230BL, входят: конденсоры темного поля, окуляры, объективы, устройства для исследований в поляризованном свете и с использованием фазового контраста, цифровые камеры, калибровочные слайды.
Основные особенности:
- Микроскоп-бинокуляр с настройкой высоты окулярных тубусов под рост наблюдателя (вращение на 360°)
- Диоптрийная подвижка на левом окулярном тубусе, возможность установки в него цифровой камеры
- Ахроматическая оптика с корректировкой на бесконечность, 5-гнездный револьвер
- Источник проходящего света – светодиод 3 Вт с регулировкой яркости и питанием от сети
- Возможность настройки освещения по Кёлеру благодаря наличию полевой диафрагмы
- Поддержка установки темнопольного и фазового слайдеров в слот конденсора
- Коаксиальный механизм фокусировки, грубая и тонкая настройка, блокировка и настройка жесткости для грубой фокусировки
- Широкая линейка дополнительных аксессуаров
Комплектация:
- Штатив со встроенным источником электропитания, источником проходящего света, механизмом фокусировки, предметным столиком, кронштейном конденсора и револьвером объективов
- Конденсор Аббе
- Бинокулярная визуальная насадка
- Объектив-ахромат, рассчитанный на бесконечность: 4x/0,10
- Объектив-ахромат, рассчитанный на бесконечность: 10x/0,25
- Объектив-ахромат, рассчитанный на бесконечность: 40x/0,65 (подпружиненный)
- Объектив-ахромат, рассчитанный на бесконечность: 100x/1,25 ми (подпружиненный)
- Окуляр 10x/18 мм с удаленным зрачком (2 шт.)
- Наглазник на окуляр (2 шт.)
- Светофильтр (4 шт.)
- Флакон с иммерсионным маслом
- Сетевой шнур питания для микроскопа
- Пылезащитный чехол
- Инструкция по эксплуатации и гарантийный талон
Поставляются по дополнительному заказу:
- Окуляр 10x/20 мм со шкалой
- Окуляр 15х/11 мм (2 шт.)
- Окуляр 16х/11 мм (2 шт.)
- Окуляр 20х/11 мм (2 шт.)
- Объектив-ахромат, рассчитанный на бесконечность: 20х/0,40
- Объектив-планахромат, рассчитанный на бесконечность: 20х/0,40
- Объектив-планахромат, рассчитанный на бесконечность: 60x/0,80 (подпружиненный)
- Фазово-контрастное устройство: фазовый конденсор, набор фазовых объективов, вспомогательный центрирующий телескоп
- Фазово-контрастное устройство: набор фазовых слайдеров, набор фазовых объективов, вспомогательный центрирующий телескоп
- Конденсор темного поля А 0,9
- Конденсор темного поля иммерсионный А 1,36–1,25
- Слайдер темного поля
- Устройство простой поляризации
- Цифровая камера
- Калибровочный слайд
- Адаптер C-mount
- Монитор
Характеристики
| Артикул | 82893 |
| Бренд | MAGUS (Магус) |
| Гарантия | 5 лет |
| EAN | 5905555017969 |
| Размер упаковки (ДxШxВ) | 43x27x63 см |
| Вес упаковки | 10 кг |
| Тип | биологические, световые/оптические |
| Тип насадки | бинокулярная |
| Насадка | Gemel (Зидентопф с вращением тубусов на 360°) |
| Угол наклона окулярной насадки | 30° |
| Диапазон увеличения, крат | 40 — 1000 |
| Увеличение, крат (опционально) | 40–1500/1600/2000 |
| Диаметр окулярной трубки, мм | 23.2 |
| Окуляры | 10x/18, удаленный зрачок 10 мм (*опция: 10x/20 мм со шкалой, 15x/11 мм, 16x/11 мм, 20x/11 мм) |
| Объективы | ахроматические, скорректированные на бесконечность: 4x/0,10; 10x/0,25; 40xs/0,65; 100xs/1,25 (масляный); парфокальная высота 45 мм (*опция: 20x/0,40; 60xs/0,80) |
| Револьверное устройство | на 5 объективов |
| Рабочее расстояние, мм | 18,89 (4x); 5,95 (10x); 0,775 (40xs); 0,36 (100xs); 2,61/8,80 (20х); 0,46 (60хs) |
| Межзрачковое расстояние, мм | 48 — 75 |
| Предметный столик, мм | 180x150 |
| Диапазон перемещения предметного столика, мм | 75/50 |
| Характеристики предметного столика | двухкоординатный механический, без выдвижной рейки |
| Возможность диоптрийной коррекции, D | ±5 (на левом тубусе) |
| Конденсор | центрируемый и регулируемый по высоте конденсор Аббе NA 1,25 с регулируемой апертурной диафрагмой и слотом для слайдера темного поля и фазового контраста; тип крепления «ласточкин хвост» |
| Диафрагма | регулируемая апертурная, регулируемая ирисовая полевая |
| Фокусировка | коаксиальная, грубая (21 мм, 39,8 мм/оборот, с механизмами блокировки и регулировки жесткости) и тонкая (0,002 мм) |
| Подсветка | светодиодная |
| Регулировка яркости | ✓ |
| Источник питания | 220±22 В, 50 Гц, сеть переменного тока |
| Тип лампы подсветки | светодиод 3 Вт |
| Светофильтры | есть |
| Диапазон рабочих температур, °С | 5...+35 |
| Возможность подключения другого оборудования | фазово-контрастное устройство (конденсор и объективы), конденсор темного поля (сухой или масляный), устройство простой поляризации (поляризатор и анализатор) |
| Уровень пользователя | для опытных, для профессионалов |
| Уровень сложности сборки и настройки | сложно |
| Назначение | лабораторные/медицинские |
| Расположение подсветки | нижняя |
| Метод исследования | светлое поле |
| Чехол/кейс/сумка в комплекте | чехол пылезащитный |
| Вес, кг | 8 |
| Габариты, мм | 200x436x400 |
- Штатив со встроенным источником электропитания, источником проходящего света, механизмом фокусировки, предметным столиком, кронштейном конденсора и револьвером объективов
- Конденсор Аббе
- Бинокулярная визуальная насадка
- Объектив-ахромат, рассчитанный на бесконечность: 4x/0,10
- Объектив-ахромат, рассчитанный на бесконечность: 10x/0,25
- Объектив-ахромат, рассчитанный на бесконечность: 40x/0,65 (подпружиненный)
- Объектив-ахромат, рассчитанный на бесконечность: 100x/1,25 ми (подпружиненный)
- Окуляр 10x/18 мм с удаленным зрачком (2 шт.)
- Наглазник на окуляр (2 шт.)
- Светофильтр (4 шт.)
- Флакон с иммерсионным маслом
- Сетевой шнур питания для микроскопа
- Пылезащитный чехол
- Инструкция по эксплуатации и гарантийный талон
Поставляются по дополнительному заказу:
- Окуляр 10x/20 мм со шкалой
- Окуляр 15х/11 мм (2 шт.)
- Окуляр 16х/11 мм (2 шт.)
- Окуляр 20х/11 мм (2 шт.)
- Объектив-ахромат, рассчитанный на бесконечность: 20х/0,40
- Объектив-планахромат, рассчитанный на бесконечность: 20х/0,40
- Объектив-планахромат, рассчитанный на бесконечность: 60x/0,80 (подпружиненный)
- Фазово-контрастное устройство: фазовый конденсор, набор фазовых объективов, вспомогательный центрирующий телескоп
- Фазово-контрастное устройство: набор фазовых слайдеров, набор фазовых объективов, вспомогательный центрирующий телескоп
- Конденсор темного поля А 0,9
- Конденсор темного поля иммерсионный А 1,36–1,25
- Слайдер темного поля
- Устройство простой поляризации
- Цифровая камера
- Калибровочный слайд
- Адаптер C-mount
- Монитор